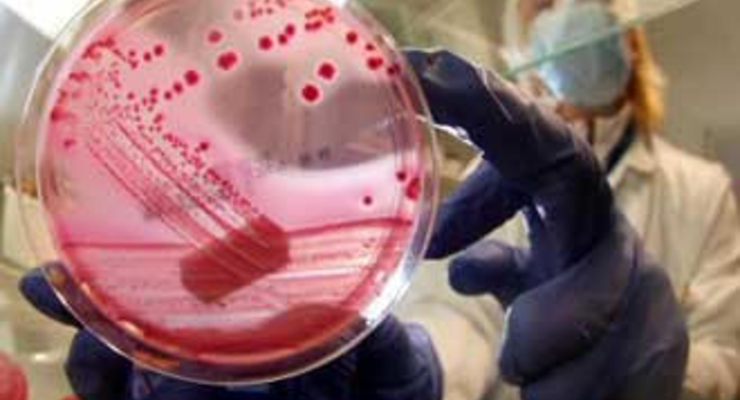
Кишечная палочка обнаружена в ручье во Франкфурте-на-Майне

В воде ручья Эрленбах во Франкфурте-на-Майне обнаружена высокопатогенная палочка ЭГЭК того типа, который вызвал волну кишечных заболеваний в Германии, сообщает агентство AFP в субботу, 18 июня, ссылаясь на власти федеральной земли Гессен. Ручей протекает неподалеку от фермерского хозяйства, на листовом салате из которого ранее также были обнаружены бактерии ЭГЭК.
По данным гессенских властей, воды из ручья не попадают в водопроводную сеть. "Поэтому опасности заражения питьевой воды не существует", - заявила 18 июня официальный представитель министерства по социальным вопросам Гессена. Каким образом бактерии попали в ручей, пока не известно. Поскольку пробы воды были взяты неподалеку от канализационной очистной станции, то нельзя исключить, что инфекция попала в воду именно оттуда, сообщили в министерстве. В настоящее время идет анализ других взятых из ручья проб воды, сообщил представитель гессенского министерства охраны окружающей среды.
Между тем появившиеся накануне результаты лабораторных анализов подтвердили факт передачи опасной палочки ЭГЭК от человека человеку через пищу. Сотрудница одной из банкетных служб несколько недель назад заразила посетителей вечеринки, на которой она работала. Через некоторое время после мероприятия заболела не только она, но и 20 из 65 гостей.
Немецкая приборостроительная компания Analytik Jena разработала аппарат, который позволяет в течение двух часов определять наличие палочки ЭГЭК на продуктах питания. По словам главы фирмы Клауса Берки (Klaus Berka), подобный "экспресс-тест" разработала команда из пяти сотрудников всего за 14 дней. Теперь его могут использовать для проведения анализов лаборатории. Пригоден он и для тестов в домашних условиях или супермаркетах.
По материалам Deutsche Welle







